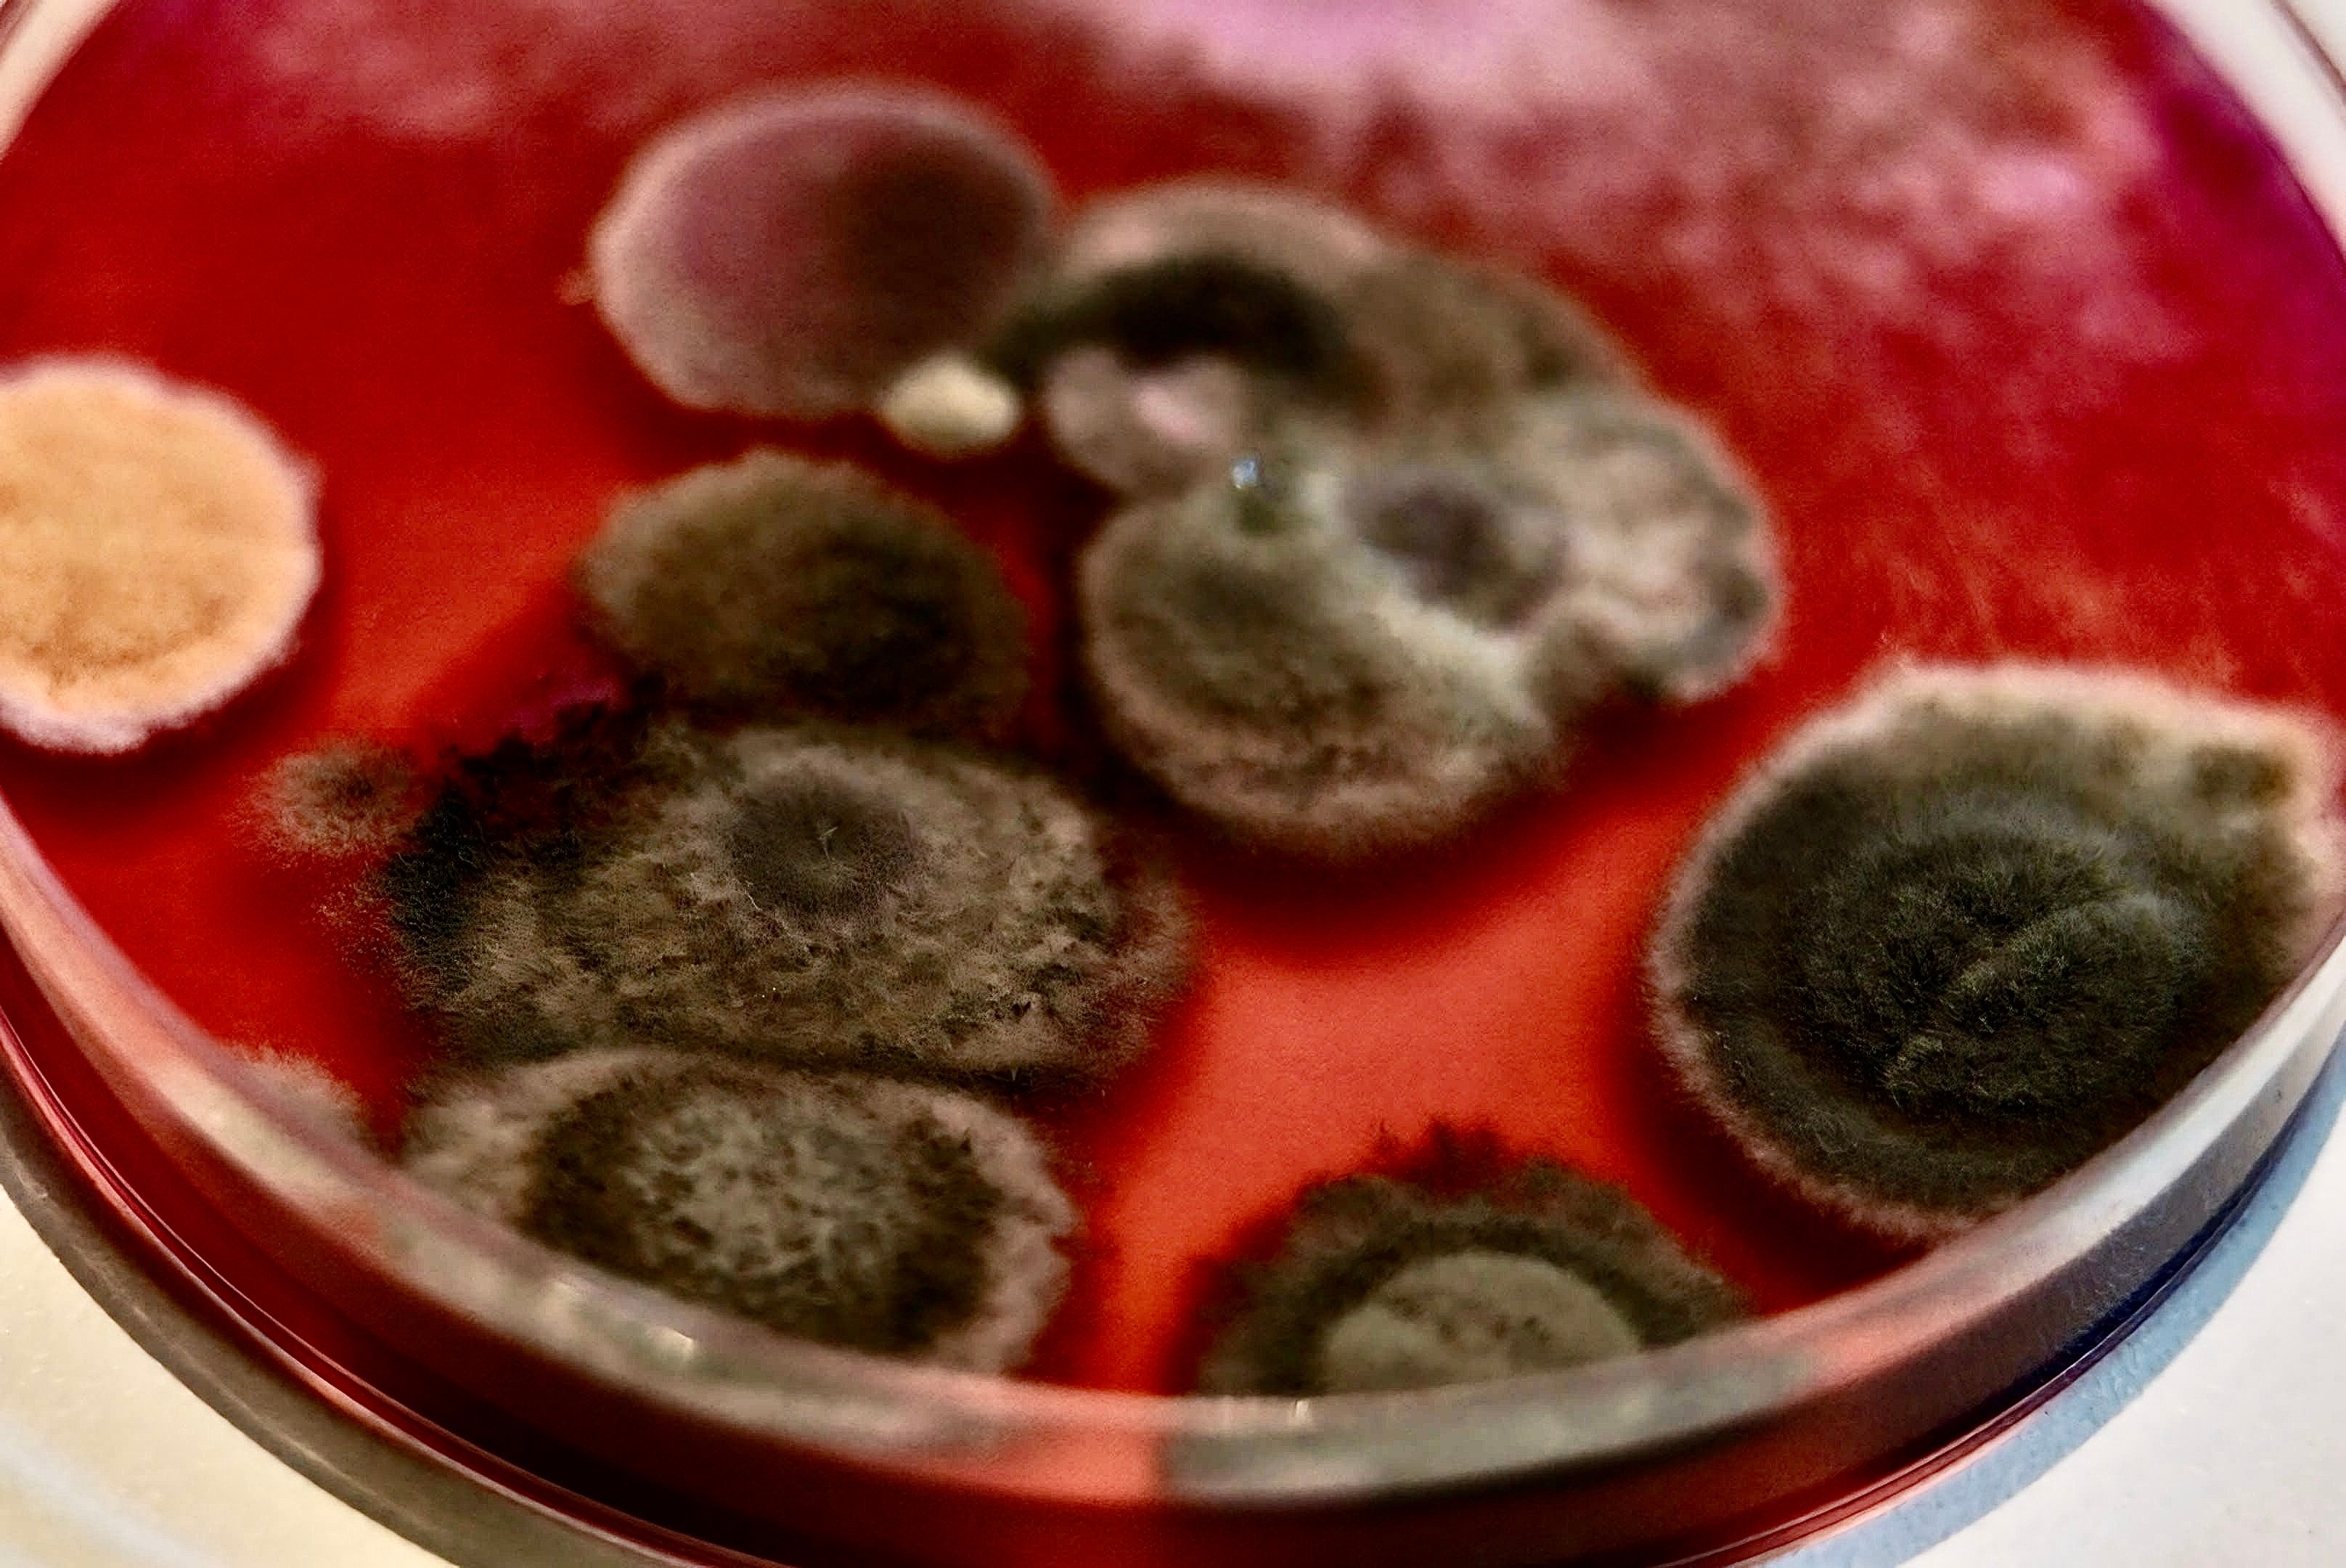

Técnicas básicas para la producción de hongos y bacterias de uso agrícola
Curso online práctico sobre la producción de hongos y bacterias de uso agropecuario, enfocado en técnicas accesibles para la elaboración de bioinsumos y abonos orgánicos.

Curso online práctico sobre la producción de hongos y bacterias de uso agropecuario, enfocado en técnicas accesibles para la elaboración de bioinsumos y abonos orgánicos.
Este curso nace de la necesidad de ofrecer a agricultores, campesinos, estudiantes, ingenieros agropecuarios y profesionales relacionados una formación accesible y práctica en la producción de microorganismos benéficos para la agricultura. A lo largo del curso, aprenderás desde los conceptos básicos hasta la elaboración y aplicación de bioinsumos y abonos orgánicos a base de bacterias y hongos, con técnicas sencillas que podrás implementar fácilmente en tu campo, huerto o proyecto académico. Queremos proporcionarte herramientas que te ayuden a mejorar la salud del suelo, controlar plagas y enfermedades de manera natural, y aumentar la productividad de tus cultivos de forma sostenible. Este curso está diseñado con un enfoque claro y didáctico, ideal para quienes buscan profundizar o complementar su formación en microbiología aplicada al agro.
Objetivos:
Contenidos:
Actividades:
Objetivos:
Contenidos:
Actividades:
Objetivos:
Contenidos:
Actividades:
Objetivos:
Contenidos:
Actividades:
Objetivos:
Contenidos:
Actividades:

Tiempo de duración: 2 horas
Fecha: Sábado 8 de Febrero 2025
Hora de inicio: 8:00 PM (Hora Bogotá)

Tiempo de duración: 2 horas
Fecha: Sábado 15 de Febrero 2025
Hora de inicio: 8:00 PM (Hora Bogotá)

Tiempo de duración: 2 horas
Fecha: Sábado 22 de Febrero 2025
Hora de inicio: 8:00 PM (Hora Bogotá)

Tiempo de duración: 2 horas
Fecha: Sábado 8 de marzo del 2025
Hora de inicio: 8:00 PM (Hora Bogotá)
Clases en vivo y acceso a grabaciones
Las clases en vivo se llevarán a cabo a través de la plataforma Zoom. Si no puedes asistir a alguna sesión, no te preocupes, ya que todas las clases serán grabadas y estarán disponibles un día después. Podrás acceder a ellas en cualquier momento, permitiéndote revisar el contenido cuantas veces necesites. Esta modalidad garantiza que puedas seguir el curso a tu propio ritmo y no perderte ninguna explicación importante.
Certificado de participación
Al finalizar el curso, recibirás un certificado de participación que avala los conocimientos adquiridos. El certificado será enviado a tu correo electrónico personal hasta un mes después de haber completado el curso, una vez verificado el cumplimiento de todas las actividades y evaluaciones. Este documento te servirá como respaldo de tu formación en técnicas de producción de hongos y bacterias de uso agropecuario.
Para inscribirte en el curso, sigue estos pasos:
Si tienes alguna duda sobre el proceso de inscripción, no dudes en contactarnos.